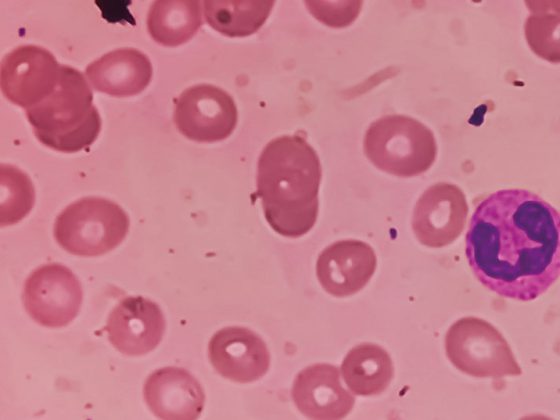
eisenmangel_istock-1379193688

Fortschritte in der Brustkrebstherapie: Neue Antikörper-Wirkstoff-Konjugate wie Trastuzumab-Deruxtecan und Sacituzumab Govitecan eröffnen vielversprechende Behandlungsoptionen für Patientinnen mit HER2-low oder HR+/HER2– Brustkrebs. Studien zeigen, dass diese innovativen Ansätze das Überleben verlängern können – ein Paradigmenwechsel in der Therapie des metastasierten Mammakarzinoms bahnt sich an.
Autoren
- Leoni Burggraf
Publikation
- InFo ONKOLOGIE & HÄMATOLOGIE
Related Topics
Dir könnte auch gefallen
- Vom Symptom zur Diagnose
Pneumologie – Covid-19: ein Rückblick
- Altersbedingte neurokognitive Störungen
Neuroprotektive Wirkungen des Ginkgo-biloba-Extrakts
Wie Herkunft und Wohnort den CF-assoziierten Diabetes fördern
- Pankreaskarzinom
Innovative Früherkennung mit Fokus auf Liquid Biopsy und KI
- Vom Symptom zur Diagnose
Abdominalschmerz – Prostataabszess
- Asthma in der Schwangerschaft
Bis zu 40% erleiden Symptomverschlechterung während der Gravidität
- Vom Symptom zur Diagnose
Komplizierte Nierenzysten
- Schweres Asthma und CRSwNP